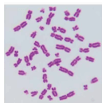
Vẽ các nhiễm sắc thể quan sát được trong một tế bào, Xác định số lượng nhiễm sắc thể trong tế bào

Vẽ các nhiễm sắc thể quan sát được trong một tế bào, Xác định số lượng nhiễm sắc thể trong tế bào
Giải Sinh 12 Bài 6: Đột biến nhiễm sắc thể - Cánh diều
Báo cáo kết quả thí nghiệm trang 38 Sinh học 12:
- Vẽ các nhiễm sắc thể quan sát được trong một tế bào. Xác định số lượng nhiễm sắc thể trong tế bào.
- Mô tả nhiễm sắc thể đột biến (nếu có).
- Trả lời câu hỏi: Bộ nhiễm sắc thể đột biến khác bộ nhiễm sắc thể thường như thế nào?
- Báo cáo kết quả thí nghiệm theo mẫu ở bài 1.
Lời giải:
- Vẽ các nhiễm sắc thể quan sát được trong một tế bào. Xác định số lượng nhiễm sắc thể trong tế bào.
→ Số lượng nhiễm sắc thể có trong tế bào trên là 47.
- Mô tả nhiễm sắc thể đột biến (nếu có): Bộ nhiễm sắc thể trên có chứa cặp nhiễm sắc thể số 21 chứa 3 chiếc thay vì 2 chiếc như bình thường.
- Trả lời câu hỏi: Bộ nhiễm sắc thể đột biến khác bộ nhiễm sắc thể thường như thế nào?
Bộ nhiễm sắc thể đột biến sẽ có số lượng hoặc cấu trúc nhiễm sắc thể khác bộ nhiễm sắc thể thường.
- Báo cáo kết quả thí nghiệm theo mẫu ở bài 1.
BÁO CÁO KẾT QUẢ THÍ NGHIỆM
QUAN SÁT ĐỘT BIẾN NHIỄM SẮC THỂ TRÊN TIÊU BẢN CỐ ĐỊNH
- Tên thí nghiệm: Thực hành quan sát đột biến nhiễm sắc thể trên tiêu bản cố định.
- Nhóm thực hiện: …………….
- Kết quả và thảo luận:
→ Số lượng nhiễm sắc thể có trong tế bào trên là 47, tăng 1 nhiễm sắc thể so với bộ nhiễm sắc thể bình thường 2n = 46 → Đây là dạng đột biến số lượng nhiễm sắc thể dạng 2n + 1.
- Kết luận: Có thể căn cứ vào các biến đổi bất thường về số lượng, cấu trúc của nhiễm sắc thể khi quan sát tiêu bản cố định để xác định các dạng đột biến cấu trúc hoặc số lượng nhiễm sắc thể.
Lời giải bài tập Sinh 12 Bài 6: Đột biến nhiễm sắc thể hay khác:
Luyện tập 1 trang 32 Sinh học 12: Hãy lấy thêm ví dụ đột biến số lượng nhiễm sắc thể. ....
Luyện tập 2 trang 34 Sinh học 12: Trình bày cơ chế đột biến gây hội chứng Klinefelter ở người. ....